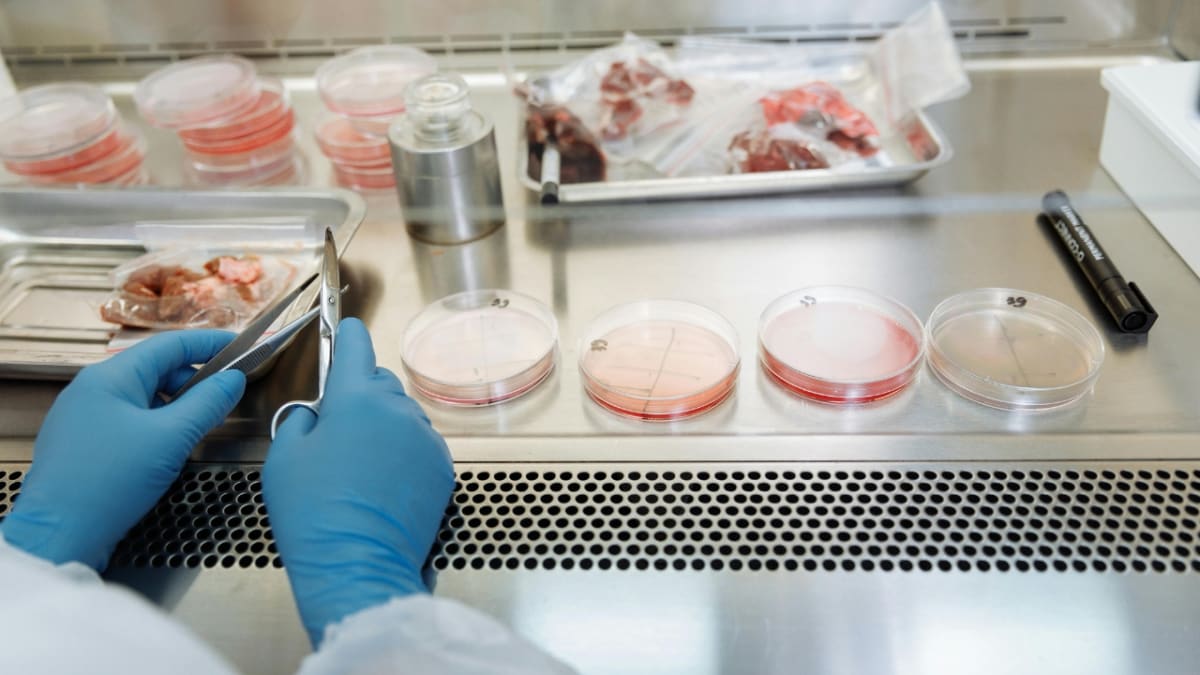
South Africa Cuts Lab-Grown Meat Costs With New Discovery

🚀
Regional: south africa breakthrough (ZA)3h ago

South Africa Cuts Lab-Grown Meat Costs With New Discovery

South African scientists just made cultivated meat cheaper to produce, bringing the country closer to sustainable food innovation.

The breakthrough could help local companies create alternative proteins without expensive imports.
Want to know more?
1/4